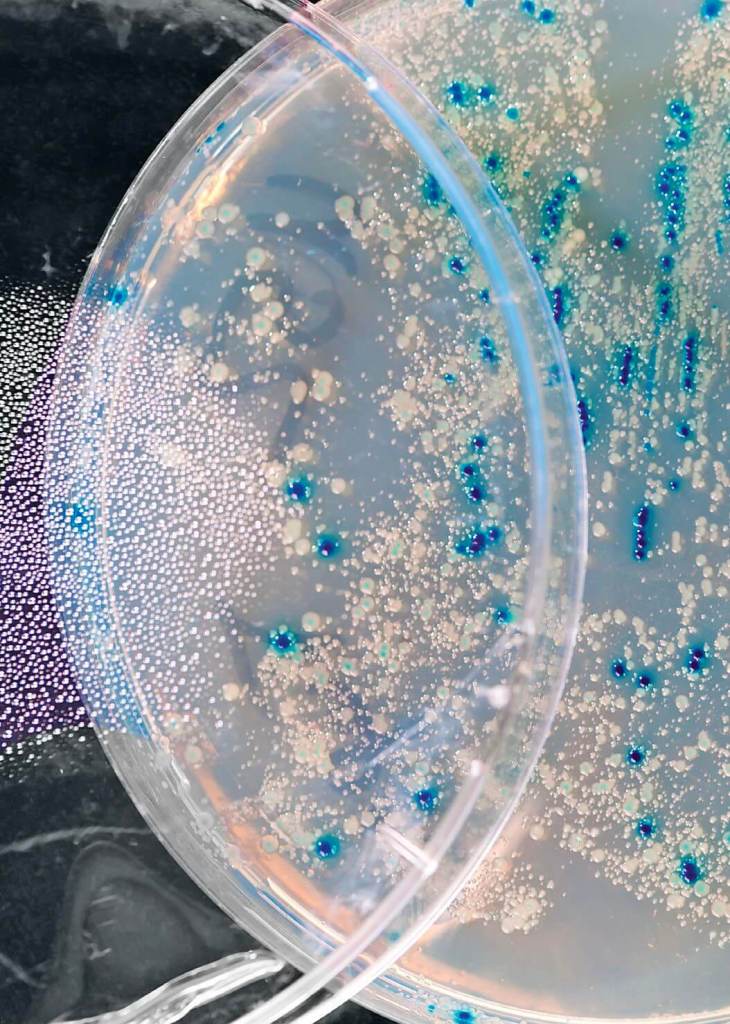

Los bacteriófagos o fagos son un grupo de virus que infectan bacterias. Son tan antiguos como la propia virología —ciencia que se dedica al estudio de los virus— y en la actualidad son organismos con un gran interés en muchos campos de la ciencia y un enorme potencial en la cura de las enfermedades que más preocupan al ser humano
Los bacteriófagos fueron unos de los primeros virus en ser descubiertos y esenciales en el desarrollo de la virología como una ciencia independiente de la microbiología. Dejemos atrás cuestiones como la generación espontánea, el descubrimiento del universo microbiano y las enfermedades infecciosas y situémonos en el contexto histórico de la edad de oro de la bacteriología, a finales del siglo XIX, con Louis Pasteur y Robert Koch como grandes exponentes. En esta época, y aunque todavía no se conocía la existencia de los mismos, ya se usaba en ciencia el término virus para referirse a todo tipo de sustancias venenosas o con capacidad para hacer enfermar.
En ese caldo de cultivo aparecen las primeras pruebas de la existencia de algún tipo de organismo distinto a los microbios, pues comienzan a detectarse enfermedades infecciosas que no pueden ser validadas con los postulados que determinaban si el origen de una enfermedad es o no bacteriana. Sin embargo, dado que nos encontramos a finales del siglo XIX, resultaba lógico pensar que si había algo que escapaba a estos criterios debía tratarse de un defecto en las técnicas utilizadas, pues pese a todas las aportaciones experimentales de Pasteur para demostrar la existencia de los microorganismos y desarrollo de técnicas asépticas, existía una gran dificultad para aislar y obtener cultivos puros de muchos de los agentes infecciosos implicados en las enfermedades, aun cuando se cumplieran los postulados de Koch.
Esta culpabilización de la falta de tecnología adecuada se acrecentó con el hecho de que se pudieran desarrollar vacunas frente a dichas enfermedades infecciosas a pesar de no haber podido cultivar el microorganismo, por lo que los microbiólogos de la época aún no se habían planteado la posible existencia de un ente no microbiano.

La importancia de las plantas y los hongos
Lo que viene a continuación es la demostración de que en la ciencia existe un fuerte vínculo entre distintas disciplinas y que su estudio interdisciplinar nos ha llevado a una época de éxitos y descubrimientos. Desde 1840, cuando hizo su aparición el tizón o mildiu de la patata en Irlanda —causante de la gran hambruna irlandesa—, provocada por un hongo (que sería identificado como Phytophthora infestans) y tras las brillantes investigaciones de Heinrich Anton de Bary, padre de la fitopatología, era conocido y aceptado que los hongos podrían causar enfermedades en las plantas.
Por otro lado, también se demostró que las bacterias podían infectar a las plantas. Así, Thomas J. Burrill descubrió el «fuego bacteriano»: una enfermedad infecciosa que afectaba a algunos miembros de la familia de las rosáceas, causada por la bacteria Erwinia amylovora (a la que él llamó Micrococcus amylovorus). Sin embargo, estos estudios, junto a los elaborados por J. H. Wakker en Países Bajos, fueron ignorados.
En este contexto hace su aparición el biólogo Dmitri Iósifovich Ivanovski, un modesto (en cuanto a recursos económicos, pero brillante en sus planteamientos) investigador del Departamento de Historia Natural de la Facultad de Física y Matemáticas de la Universidad de San Petersburgo. Era un alumno brillante que conocía a los clásicos de las ciencias naturales y la filosofía y cuyo desempeño en el laboratorio de fisiología y anatomía vegetal no pasó desapercibido para el profesor Andréi Nikoláievich Bekétov (que llegaría a ser decano de Historia Natural en la universidad). Así pues, Beketov envió al joven Ivanovski y a su compañero Polovtsev a Ucrania y Besaravia a estudiar la enfermedad del mosaico del tabaco, que estaba causando estragos en las plantaciones.
El mosaico del tabaco era una enfermedad descrita por Adolf Mayer, a la que, sin embargo, no había podido asignársele un agente etiológico, pese a demostrarse su carácter infeccioso (más tarde se descubriría que el agente infeccioso era un virus: el virus del mosaico del tabaco, primer virus en ser identificado como tal).
Ivanovski pasó un extracto de plantas infectadas utilizando un filtro de porcelana porosa desarrollado en 1884 por Chamberland, discípulo de Pasteur, que retenía a las bacterias y, por tanto, no había necesidad de calentar para esterilizar. Ivanovski aplicó el filtrado resultante a plantas sanas que desarrollaron la enfermedad, demostrando la existencia de organismos o partículas filtrables distintos de las bacterias.
En cualquier caso, antes de conocer al agente causal, Martinus Willem Beijerinck demostró que no se trataba de ninguna partícula, sino de un organismo, pues con el filtrado conseguía transmitir de forma ilimitada la enfermedad en las plantas. A este organismo, en un alarde de originalidad, lo llamó contagium vivum fluidum.

Microbiano vs. no microbiano
Los estudios hechos sobre plantas y otros, como los de Peyton Rous, que logró reproducir tumores en pollos sanos usando un filtrado de células de sarcoma de pollos infectados; o los de Loeffler y Frosch, que determinaron que estos entes filtrables no eran toxinas, sino organismos distintos de las bacterias, pues eran filtrables y con capacidad de replicarse y mantener su infectividad, hicieron que se empezara a plantear entre los científicos el conflicto «microbiano versus no microbiano» para definir a estos organismos filtrables. El concepto «microbiano» reconocía a estos entes como microorganismos, mientras que el de «no microbiano» los definía como «sustancias tóxicas no celulares».
Así que, ¿cómo estudiar y definir a unos organismos no microbianos que, aunque infectaban células no eran visibles al microscopio de la época ni se podían cultivar? El reto de descubrir a los virus —a los bacteriófagos entre ellos—, sin duda, estaba ahí, precisamente, en la dificultad intrínseca a su naturaleza.
Descubrimiento de los bacteriófagos... y polémica
Se atribuye el descubrimiento de los bacteriófagos a dos científicos de manera independiente, es decir, que los descubrieron sin conocer el trabajo uno del otro. Pero ¿es esto cierto? Veamos.
La primera persona que pone en conocimiento de la comunidad científica la existencia de organismos filtrables no microbianos con capacidad para destruir bacterias (a los que él ya denominaba virus ultramicroscópicos, aun sin haber sido descrita la naturaleza de los virus) es el científico británico Frederick Twort, brillante microbiólogo del Brown Institute for Animals de Londres.
Frederick Twort llevaba años cultivando estos virus ultramicroscópicos, consciente de la dificultad a la que se enfrentaba, pues la patogenicidad era la única prueba que existía de la presencia de estos agentes, ya que no eran visibles al microscopio. Trataba de encontrar lo que denominaba «sustancia esencial»: algo que tenían las bacterias y que era absolutamente necesario para el crecimiento in vitro de estos misteriosos y esquivos organismos. Para demostrarlo utilizó en sus experimentos el virus vaccinia de la vacuna contra la viruela, y la sembró en medio de cultivo para bacterias. En algunos de estos cultivos obtuvo zonas de aspecto acuoso y colonias de micrococos que no pudo subcultivar, pero que con el tiempo se volvían vidriosas y transparentes. Observando estas regiones acuosas a través del microscopio pudo ver que se mostraban como gránulos rojizos con la tinción de Giemsa, así que Twort pensó que podía tratarse de restos de bacterias muertas.
Pero, a diferencia de un proceso degenerativo ordinario, estos cúmulos rojizos comenzaban en el exterior de la colonia e iban hacia el interior, acabando con todos los micrococos, que eran reemplazados por estos gránulos teñidos de rojo. En un nuevo intento, decidió cultivar esas regiones vítreas, pero en lugar de crecerlas sobre el medio de cultivo lo hizo sobre un cultivo de colonias de micrococos. Lo que observó en estos experimentos es que aquello que tenía la capacidad de matar a las bacterias podía propagarse entre colonias de manera indefinida, pero era incapaz de crecer por sí mismo en ningún otro medio si en este no había bacterias. Además, demostró la especificidad de este agente por los micrococos, pues mostraba muy poco efecto lítico sobre Staphylococcus aureus y Staphylococcus albus y nada de efecto sobre Escherichia coli, estreptococos, bacilos tuberculosos o levaduras.
Twort publicó los resultados en The Lancet en 1915 y en él discute si el causante de la destrucción de las bacterias (el famoso virus ultramicroscópico) podría ser una bacteria diminuta, una ameba o una enzima con poder de crecimiento.
Dos años después de la publicación de estos resultados, Félix d'Hérelle, microbiólogo francés asentado en Canadá, describe el mismo efecto en bacilos de Shiga (Shigella dysenteriae) aislados de un paciente con disentería y presenta sus resultados en la Academia Francesa de las Ciencias. A este antimicrobio invisible con capacidad de destruir cultivos de Shigella lo describe como un «bacteriófago obligado» con un «parasitismo estrictamente específico», acuñando así el término bacteriófago («devorador de bacterias»). Es indudable la aportación de d'Hérelle al descubrimiento de los bacteriófagos, sobre todo porque su investigación tuvo más repercusión en la comunidad científica que la de Twort, pero cuesta creer que, dada la trayectoria como microbiólogo de Frederick Twort, de la institución donde desarrollaba su trabajo y de la publicación en The Lancet dos años antes, el científico francés desconociera el trabajo, métodos y resultados obtenidos por el británico.
Sin embargo, d'Hérelle sí se muestra como un auténtico pionero (no solo porque acuña el término con el que se les conocería de aquí en adelante) cuando observa que la presencia de estos bacteriófagos está directamente relacionada con la disminución o eliminación de disentería en pacientes afectados. Incluso se atreve a ensayar con conejos sanos, a los que, inoculándoles fagos purificados de animales enfermos, los protege frente a la infección por Shigella. Este podría considerarse como el primer ensayo de fagoterapia para el tratamiento de infecciones frente a bacterias.

gran hambruna irlandesa de
1845 a 1852. - Album
La naturaleza de los genes, el grupo de los fagos y los Nobel
A principios del siglo XX, la naturaleza del gen se convirtió en una cuestión fundamental en el campo de la biología, por lo que el estudio de esta estructura atrajo a las mentes más brillantes de la época, que buscaron modelos sencillos y fáciles de estudiar para poder arrojar luz sobre esta trascendente cuestión. Y, una vez más, los fagos estarían detrás de tamaño misterio.
Casi dos décadas después de los descubrimientos de Twort y d'Hérell, el bioquímico húngaro Max Schlesinger logra, en 1933, aislar y purificar por primera vez un bacteriófago, el fago WLL, con el que demostraría que los fagos están formados por proteína y ácido desoxirribonucleico (ADN). Sin embargo, la naturaleza infecciosa de los fagos seguía siendo un misterio que no sería desentrañado hasta los años cincuenta por Martha Chase y Alfred Day Hershey con su «experimento de la licuadora». Estos investigadores del Cold Spring Harbor Laboratory demostraron que el elemento viral heredable era el ácido nucleico y no la proteína: era el ADN el que penetraba en las bacterias e iniciaba el ciclo infectivo del virus. Estos resultados tuvieron una repercusión trascendental: acababan de demostrar que los genes, el material genético, la información heredable, estaban compuestos de ADN y no de proteínas.
La sencillez estructural y genética de los fagos, junto a la aparición de la microscopía electrónica con la que los virus se hicieron visibles, hicieron de estos un modelo ideal para el estudio de la expresión génica y la morfogénesis, atrayendo a su uso a grandes científicos como Salvador Luria y Max Delbrück, quienes, junto a Alfred Day Hershey fueron conocidos como «el grupo de los fagos». Estos tres investigadores obtuvieron el premio Nobel de Medicina o Fisiología en 1969 por sus «descubrimientos relacionados con los mecanismos de replicación y estructura genética de los virus».
Este es el inicio y época dorada de la biología molecular y la biotecnología, donde se sucedieron grandes descubrimientos en los que los bacteriófagos estuvieron implicados de manera notable. Tanto es así que sin ellos no hubiera sido posible el premio Nobel de Fisiología o Medicina anteriormente mencionado o el que en 1965 fue otorgado a François Jacob, Jacques Monod y André Lwoff «por sus descubrimientos sobre el control genético de la enzima y síntesis de virus», ya que para ello utilizaron como modelo de estudio el fago λ; un bacteriófago muy conocido y utilizado que infecta a la bacteria Escherichia coli. O el premio Nobel de Fisiología o Medicina que en 1978 fue entregado a Werner Arber, Daniel Nathans y Hamilton Smith por «el descubrimiento de enzimas de restricción y su aplicación a problemas de genética», ya que sin la ADN ligasa del bacteriófago T4 estas aplicaciones no hubiesen sido posibles.

El avance de la ciencia gracias a los fagos
Es innegable el impacto que han tenido los fagos en el avance de la ciencia desde el su descubrimiento hasta la actualidad y su utilidad para resolver desde problemas básicos y esenciales (como la naturaleza del material genético) hasta su uso para la resolución de los problemas más graves con los que el ser humano se enfrentará en los próximos años. Uno de estos es el de la resistencia bacteriana a los antibióticos, un problema global que supone hoy día una de las mayores amenazas para nuestra salud.
La terapia fágica, es decir, el uso de fagos para tratar enfermedades bacterianas ha resurgido en los últimos años como una alternativa al uso de antibióticos para reducir o minimizar la resistencia al uso de los mismos. En salud humana se han hecho experimentos con éxito para usar fagos en el tratamiento de infecciones en el oído o quemaduras que han sido infectadas por Pseudomonas aeruginosa o Escherichia coli. En el caso de la seguridad alimentaria y la agricultura, los fagos también se plantean como una opción viable y efectiva para proteger los alimentos de consumo humano y animal de la bacteria Listeria monocytogenes, microorganismo causante de la listeriosis, una de las zoonosis alimentarias con más mortalidad.
Los bacteriófagos también están siendo utilizados para el desarrollo de métodos diagnósticos más eficaces e incluso algunos productos procedentes de los fagos, como pueden ser las endolisinas del fago 52, cuya acción enzimática está resultando de utilizar para la destrucción de algunos tipos de bacterias gramnegativas y el tratamiento de infecciones por Staphylococcus aureus.
La especificidad de los fagos en cuanto a los huéspedes que parasita y su gran eficacia en el proceso de inserción del material genético en el interior de la bacteria a la que infecta hace de este grupo de virus un arma letal que juega a nuestro favor en la lucha contra las infecciones bacterianas. Y es que los fagos pueden ser usados como vectores para introducir en bacterias patógenas desde moléculas letales como genes que codifican proteínas con actividad endonucleasa (como la nucleasa Cas del sistema CRISPR/cas), hasta proteínas o toxinas. De hecho, esta capacidad que tienen los fagos también puede ser utilizada de forma complementaria a los tratamientos antibióticos mediante la introducción de genes que aumenten la concentración de un fármaco en el sitio adecuado y en las células específicas, mejorando así la eficacia y el rendimiento del fármaco.
El uso de anticuerpos para el tratamiento de enfermedades, que se conoce como inmunoterapia, no es nada nuevo. Sin embargo, una de las formas de presentación de antígenos más útiles que existen en la actualidad es lo que se conoce como phage display o «tecnología de presentación en fagos». Esta consiste en incorporar al genoma de un fago (normalmente se usa el fago fd o el M13) un gen que codifica para una proteína (ligando) que nos interesa que este exprese en su superficie cuando el fago infecte a su bacteria huésped.
De esta manera estará presente y disponible para que se una al receptor de la molécula diana que nos interesa, que puede ser un antígeno al que neutralizar o para la generación de anticuerpos específicos frente a un antígeno determinado. Un ejemplo es el uso de esta técnica en el tratamiento de una de las enfermedades que más nos preocupan: el cáncer. Existen fagos modificados genéticamente que expresan en su cápside ligandos frente a antígenos presentes en la superficie de células tumorales. De esta manera, la unión del fago con las proteínas tumorales activará el sistema inmunitario para que sea este el que elimine las células cancerígenas.
Los bacteriófagos son un grupo de organismos de los más abundantes de la Tierra, están presentes en todos los ambientes imaginables y su contribución al avance de la ciencia es más que notable. Además, son agentes muy interesantes para la lucha contra la resistencia a los antibióticos, como terapia para algunas infecciones bacterianas e incluso contra algunos tipos de cánceres. He aquí, por tanto, múltiples motivos por los que acercarse al curioso universo de estos seres tan diminutos como fascinantes.